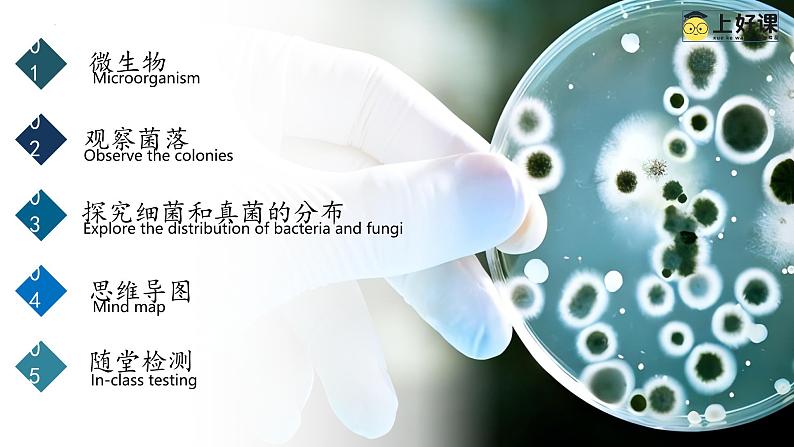

初中生物人教版(2024)七年级上册(2024)第一节 微生物的分布精品ppt课件
展开
这是一份初中生物人教版(2024)七年级上册(2024)第一节 微生物的分布精品ppt课件,共49页。PPT课件主要包含了微生物,生活情景,观察菌落,思维导图,随堂检测等内容,欢迎下载使用。
空间站中的水资源极为珍贵。我国空间站设有冷凝水收集与处理系统、尿处理系统等,以实现水的循环利用。但在使用回收水之前,航天员需要检测水样,其中一项是检测水中的微生物,并将结果作为判断水质的重要依据。此外,航天员还会检测空间站内空气、设备表面的微生物。
想一想 议一议:1. 什么是微生物?说说你知道的微生物有哪些。2. 航天员为什么要检测回收水中和空间站内的微生物?微生物与人类健康有什么关系?3 . 你还能提出什么问题?
行业PPT模板http/hangye/
Micrrganism
怎样才能用肉眼看到手上的细菌?
细菌的个体微小,大部分真菌的个体也很微小,为便于观察和检测,可以在培养皿中加入适于细菌或真菌生长的物质,制成固体培养基来培养。在适宜条件下,培养基上的细菌和真菌会迅速繁殖,形成肉眼可见的菌落--由一个或多个细菌或真菌繁殖后形成的肉眼可见的子细胞群体。
电子显微镜观察或高倍显微镜
Observe the clnies
绒毛状、絮状或蜘蛛网状
白、红、褐、绿、黑、黄等不同颜色
比细菌菌落大几倍到几十倍
阅读教材99页完成表格
区分细菌菌落和真菌菌落
试一试:判断下列菌落是细菌还是真菌菌落?
03 探究细菌和真菌的分布
Explre the distributin f bacteria and fungi
生活环境中都有细菌和真菌吗?哪种环境中更多一些?
如果请你和小组成员帮幼儿园的老师想个办法,让小朋友们知道手上就有细菌或真菌,饭前必须洗手,你有什么办法?
培养细菌和真菌的一般方法
牛肉汁等(含有营养物质)+琼脂(煮沸后能凝固的物质)
想一想:牛肉汁的作用是什么?
想一想:为什么要进行高温灭菌?
想一想:为什么要等冷却后再接种?
想一想:培养时为什么需要恒温?
将少量细菌或真菌放在培养基上的过程。
提供营养物质和生存空间
杀死培养基和培养皿上原有的细菌和真菌
目的:防止高温杀死接种的细菌或真菌
洗手前后的细菌和真菌一样多吗?
洗手前后的细菌和真菌一样多。
①配制培养基3套,贴上标签:洗手前、洗手后、空白对照。
②打开培养皿,先用无菌棉棒在脏手心处擦取,然后在“洗手前”培养基上轻轻涂抹几下,盖好;用另一支无菌棉棒在洗净的手心擦取,然后在“洗手后”培养基上涂抹几下,盖好;“空白对照”培养基不做任何处理。
③把3套培养皿一起放到恒温箱或者室内温暖处培养3~4天。
想一想:细菌和真菌的生活需要哪些基本条件?
空白对照 洗手前 洗手后
只要一组对照实验得到的结果是否可靠?如何增加实验结果的准确性?
材料用具装有牛肉汁培养基的培养皿(经高温灭菌,每组两套)、无菌棉棒、标签纸、放大镜等。
防止环境中的杂菌污染培养基;
一组接种(实验组),另一组不做任何处理(空白对照)
在标签纸上标出组别、实验日期等,将标签贴在培养皿的底面。在各组选定的环境中采集样品。例如,在教室、操场、食堂、草 地、林地等地方,打开培养皿,将培养皿暴露在空气中5~10分钟,盖好。又如,用无菌棉棒蘸取池塘水、土壤或擦拭口腔内部、手心等处,在培养基上轻轻涂抹。
便于辨认和观察记录
应考虑好放在什么样的环境条件下培养。两套装有培养基的培养皿都需要在同一环境下培养吗? 设计观察记录的表格,计划好观察的时间、次数。
放在恒温环境(根据菌种选择温度,20℃-40℃之间)
需要,控制单一变量
为什么培养用的培养皿和培养基,在接种前必须高温处理?为什么要用无菌棉棒?
对培养皿和培养基进行高温灭菌,杀死其中原有的细菌和真菌,才能保证实验中培养基上长出的菌落来自取样地。
实验中用无菌棉棒的目的是为了防止棉棒上的杂菌污染培养基。
什么环境条件下可能没有细菌和真菌?在这个探究中,有这样的情况存在吗?为什么?
只有在很极端的环境下可能没有细菌和真菌,我们的日常生活中很难有这样的环境。
在这个探究中,经过高温灭菌且保持密封的培养皿中是无菌的,因为其中原有的细菌和真菌已被高温杀死,密封又可以防止其他微生物进入培养皿。
根据各组的探究结果进行总结:细菌和真菌的生活需要哪些基本条件?
特殊条件:氧气(例如有些细菌必须在无氧条件下生存)
水分 适宜的温度 有机物
细菌和真菌的生活需要的基本条件是:水、营养物质、适宜的温度和一定的生存空间。
有的细菌和真菌还要求某些特定的生活条件,如有些细菌必须在无氧条件下才能生存,如乳酸菌等。
科学研究发现,在寒冷的极地、滚烫的热泉水中,也有细菌和真菌的踪迹。
想一想:这说明细菌的分布有什么特点?
细菌和真菌的分布情况:
细菌和真菌生活的基本条件
水、营养物质、适宜的温度和一定的生存空间
氧气是不是所有微生物生存的必要条件呢?
乳酸菌是异养厌氧型细菌,加水封口可以营造无氧环境,有利于乳酸菌的生存。
Mind map
In - class testing
一、概念检测结合本节你所做的探究活动,判断下列说法是否正确。(1)培养基中的牛肉汁可为细菌和真菌提供营养物质。 ( )(2)细菌和真菌都能够形成菌落,因此无法从菌落上区分细菌和真菌。( )
二 、拓展应用1.真空包装的食品耐储存,为什么?日常生活中防止食品腐败的方法还有哪些?说说其中的生物学道理。
许多细菌和真菌的生活需要空气(主要是其中的氧气),真空包装中几乎没有空气,不利于需氧细菌和真菌活,因此真空包装可以起到防止食品腐败的作用。
2.康康洗手前和洗手后,分别用同一只手在两个配方相同、经高温灭菌 的培养基上各按了一下,并迅速盖上培养皿;然后将两个培养皿放在适宜且相同的温度下培养,几天后形成了如下图所示的菌落。该实验现象说明什么?这对你做好个人卫生有什么启示?
该实验现象说明手上有细菌和真菌,洗手可以有效减少手上的细菌和真菌。这提示我们要注意个人卫生,平时要勤洗手,餐前必须洗手。
1.在下列哪种环境中,霉菌最容易生长?( )A.冰箱里的食物B.潮湿的皮衣C.潮湿的粉笔D.煮沸但密封的鸡肉汤
2.在教室、车站等不同的地方打开培养皿,暴露在空气中5﹣10分钟,再盖上盖封好,属于培养细菌和真菌一般方法步骤中的( )A.接种B.培养培养基C.灭菌D.放在适宜环境下培养
相关课件
这是一份初中生物人教版(2024)七年级上册(2024)第一节 微生物的分布备课课件ppt,共27页。PPT课件主要包含了学习目标,课堂导入,思考讨论,什么是微生物,什么是菌落,观察菌落,常见的细菌菌落,常见的真菌菌落,分布广泛无处不在,生存基本条件等内容,欢迎下载使用。
这是一份人教版(2024)七年级上册(2024)第一节 微生物的分布评优课教学ppt课件,文件包含231微生物的分布-初中生物七年级上册同步教学课件人教版2024pptx、231微生物的分布教学设计docx等2份课件配套教学资源,其中PPT共26页, 欢迎下载使用。
这是一份初中生物人教版(2024)七年级上册(2024)第一节 微生物的分布精品ppt课件,共30页。PPT课件主要包含了微生物等内容,欢迎下载使用。
